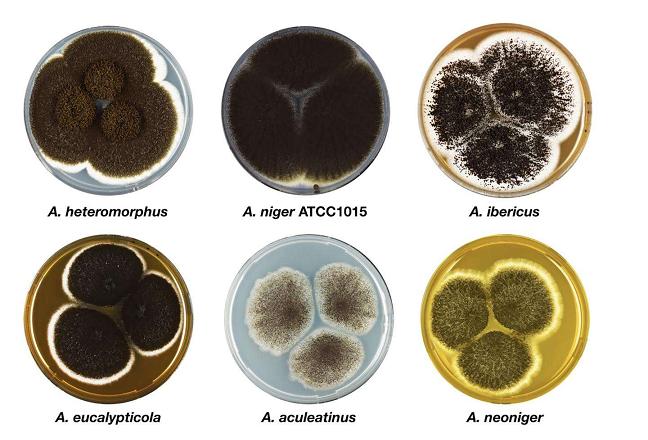
Microbial iron removal

In the field of
silica sand processing and
sand washing plant, microorganisms can effectively remove iron from silica sand.
Silica/quartz sand is a kind of non-metallic mineral, which is a hard, resistant and chemically stable silicate mineral. Its main mineral composition is SiO2. The color of silica sand is milky white, or colorless and translucent. Its hardness is 7. Quartz sand is an important industrial mineral raw material. It is a non-chemical dangerous product. It is widely used in glass, casting, ceramics and refractories, smelting ferrosilicon, metallurgical flux, construction and chemical industry. Industry, plastics, rubber, abrasives and other industries.

With the progress of science and technology, the industries of photovoltaic power, electronic industry, optical communication, SiO2 thin film materials, large-scale and ultra-large-scale integrated circuits, lasers, aerospace, military and other industries are developing rapidly, and the demand for high-grade quartz raw materials is very large. However, due to the high quality requirements of these special quartz raw materials, the demand content is usually more than 99.9%, or even 99.99%.
Quartz sand contains iron impurities, which must be removed if
high purity quartz sand is to be obtained. The magnetic separation process in the existing technology can only remove magnetic minerals including conjoined particles, such as hematite, limonite, biotite, ilmenite, pyrite and garnet, while the removal effect of thin film iron or impregnated iron on the surface of quartz sand particles is not ideal.
Microbial iron removal process
Removal of thin film iron or impregnated iron on the surface of quartz sand particles by microorganism is a newly developed technology for iron removal. The results show that the microorganisms such as Aspergillus niger, Penicillium, Pseudomonas piriformis, Bacillus, Bacillus polymyxobacteria and Micrococcus lactis have achieved good results in the removal of iron oxide on quartz surface. Among them, Aspergillus Niger is the most effective. Excellent, the removal rate of Fe2O3 can reach 88.8%, and the content of Fe2O3 in quartz sand can reach less than 60 ppm. It was also found that iron leaching with pre-cultured medium of bacteria and raspberry fungi was more effective than iron leaching with pre-cultured medium of bacteria and raspberry fungi.

Iron removal by Aspergillus Niger
Sinonine focused on the detailed process of removing iron from quartz sand by Aspergillus niger. After many tests and production verification, the following reliable process was obtained.

1.Quartz sand ore is grinded to be 0.4-0.1 mm by
rod mill, named as slurry A.
2. Surfactant (13-carbon isool ether, polyoxyethylene ether or sodium fatty acid) with a mass ratio of 0.005-0.01% was added to pulp A. Named as slurry B.
3.Mixture C was obtained by adding Aspergillus Niger liquid to pulp B. The concentration of Aspergillus Niger liquid was OD=0.4-0.6, and the mass ratio was 0.05%-0.1%.
4. Mixture C is placed in a leaching
conditioning tank for stirring leaching.
5.A mixture of oxygen and carbon dioxide (oxygen: carbon dioxide = 4:1 in volume ratio) is continuously added to mixture C and stirred at the same time.
6. The quartz sand after leaching and stirring is put into the
attrition scrubber and washed with water. Then it is put into the
spiral sand washing machine for cleaning.
7.dewatering the concentrate, the final silica sand product with low iron is obtained.
Technology advantage of Microbial iron removal process
Microbial iron removal method was used to leach iron from crushed quartz sand by Aspergillus niger. Film iron or impregnated iron on the surface of quartz sand particles could be removed. The removal rate of Fe2O3 was above 88%, and the grade of Fe2O3 in quartz sand was as low as 0.006%.
In this production process, the concentration of quartz sand particles and Aspergillus Niger in pulp can make Aspergillus Niger give full play to its iron removal effect and increase the removal rate of Fe2O3.
In the microbial iron removal process of quartz sand, surfactant is added to the pulp to increase the hydrophilicity of minerals, facilitate the contact between bacteria and minerals, promote the leaching effect of bacteria, and greatly shorten the leaching time of bacteria.

In the process of microbial iron removal from quartz sand, the mixture of oxygen and carbon dioxide is continuously added in the process of microbial leaching, and the volume ratio of the two gases is optimized, which can maintain the necessary conditions for microbial reproduction and activity and improve the effect of iron removal.
Suggestion: Fused quartz sand belongs to high-end quartz sand products, whose market demand exceeds supply. When producing fused quartz sand, you should study quartz raw material, which has great influence on producing high-purity fused quartz sand.